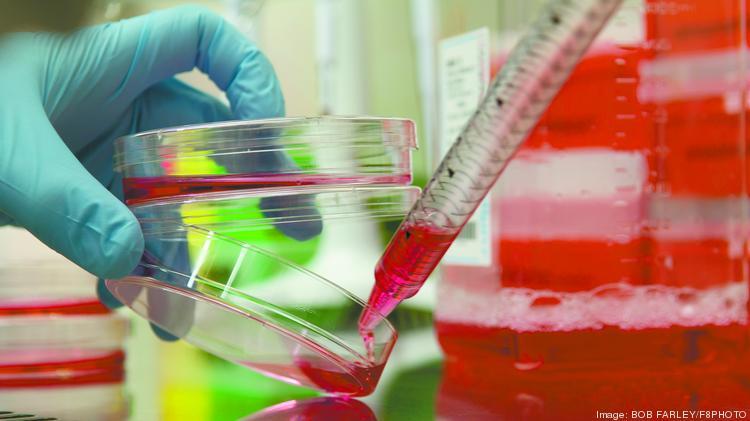
美国一基因工程公司称已完成新冠病毒疫苗研发

美国一基因工程公司称已完成新冠病毒疫苗研发
Greffex宣布完成了一种新型冠状病毒疫苗的研发。图据《纽约邮报》
Greffex宣布完成了一种新型冠状病毒疫苗的研发。图据《纽约邮报》
据《纽约邮报》20日报道,位于美国得克萨斯州休斯顿的一家基因工程公司Greffex宣布,已经完成了一种新型冠状病毒疫苗的研发。Greffex公司总裁兼首席执行官约翰·普莱斯在接受采访时表示,公司的科研人员已于本周完成了疫苗的研制工作。
报道称,疫苗将由必要的政府机构,包括美国的FDA以及其他受影响的国家的监管机构,进行动物实验。普莱斯表示,出于安全考虑,Greffex没有使用灭活或减毒病毒来制作疫苗,取而代之的是广泛用于治疗各种传染病或癌症的腺病毒载体疫苗。腺病毒是病毒性呼吸道感染最常见的原因之一,占感冒的2%到5%,因此它们也广泛用于疫苗的制造。
据报道,普莱斯表示,如果疫苗获批准,Greffex将免费提供给受影响最严重的国家。现在,候选疫苗已就位,接下来将在动物身上进行测试,然后开始第一阶段的临床试验,接着还有另外两个阶段的人体试验,最后才能得到FDA的批准。尽管Greffex尚未公布其时间表,但大多数估计认为,测试和生产可能需要18个月到两年的时间。
红星新闻记者 王雅林 徐缓 编译
相关阅读:
全球科学家竞相研发
国家卫健委称5条技术路线正同步研究
在新冠病毒肺炎疫情爆发后,全世界科学家竞相开发疫苗。19日,美国得克萨斯大学奥斯汀分校和美国国家卫生研究院的研究人员发表在顶级学术期刊《科学》杂志上的论文称,研究人员已确定了新型冠状病毒用来入侵人类细胞的一种关键蛋白质的分子结构,文章称“这一‘突破性’的成果可能是开启新冠病毒疫苗成功之门的钥匙。”
据新华社报道,上述研究团队已将这一结构的原子坐标数据发送给全球多家实验室,其中多数来自中国,目前已有大约25家中国实验室要求获取相关资料。
21日,在中国国务院应对新冠肺炎疫情联防联控机制新闻发布会上,中国国家卫健委副主任曾益新表示,中国已协调各方力量组成疫苗的研发攻关团队,在尊重科学、保障安全的前提下,最大限度缩短研发时间,力争早日投入使用。
曾益新介绍,目前疫苗研发5条技术路线在同步开展,分别是灭活疫苗、基因工程重组亚单位疫苗、腺病毒载体疫苗、核酸疫苗、减毒流感病毒载体疫苗。其中,减毒流感病毒载体疫苗如果研制成功,将可以同时预防新冠病毒感染和流感,临床意义非常大。
目前,部分项目已进入到动物试验阶段。如果疫情需要,可按有关法律来启动疫苗应急使用和应急审评审批的程序。在确保安全有效可及的前提下,估计最快在今年4到5月份可有部分疫苗进入临床试验,或在特定条件下争取进入应急使用。
()




